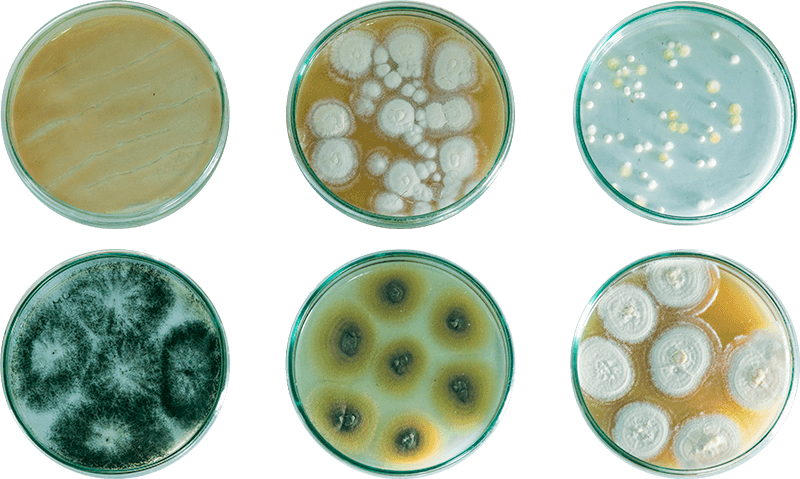

Sobre a Dillon Biotecnologia
A Dillon Biotecnologia é uma empresa nacional com experiência na produção e desenvolvimento de insumos microbiológicos, com foco em Biodefensivos e Nutrição de Plantas. Fundada em 1999, como ECCB Insumos Biológicos, na Incubadora da Universidade de Caxias do Sul, somos uma das pioneiras no mercado de controle biológico no Brasil.
Oferecemos tecnologias de manejo altamente eficientes, baseadas em ciência e na natureza, para uma agricultura mais sustentável.